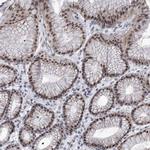
SART1 Antibody in Immunohistochemistry (Paraffin) (IHC (P))

Search
Invitrogen
SART1 Polyclonal Antibody
{{$productOrderCtrl.translations['antibody.pdp.commerceCard.promotion.promotions']}}
{{$productOrderCtrl.translations['antibody.pdp.commerceCard.promotion.viewpromo']}}
{{$productOrderCtrl.translations['antibody.pdp.commerceCard.promotion.promocode']}}: {{promo.promoCode}} {{promo.promoTitle}} {{promo.promoDescription}}. {{$productOrderCtrl.translations['antibody.pdp.commerceCard.promotion.learnmore']}}
产品信息
PA5-56664
种属反应
宿主/亚型
分类
类型
抗原
偶联物
形式
浓度
规格
纯化类型
保存液
内含物
保存条件
运输条件
RRID
产品详细信息
Immunogen sequence: RRVKKIRKKE KEVVVRADDL LPLGDQTQDG DFGSRLRGRG RRRVSEVEEE KEPVPQPLPS DDTRVENMDI SDEEEGGAPP PGSPQVLEED EAELELQKQL EKG
Highest antigen sequence identity to the following orthologs: Mouse - 85%, Rat - 83%.
靶标信息
This gene encodes two proteins, the SART1protein expressed in the nucleus of the majority of proliferating cells, and the SART1protein expressed in the cytosol of epithelial cancers. The SART1protein is translated by the mechanism of -1 frameshifting during posttranscriptional regulation; its full-length sequence is not published yet. The two encoded proteins are thought to be involved in the regulation of proliferation. Both proteins have tumor-rejection antigens. The SART1protein possesses tumor epitopes capable of inducing HLA-A2402-restricted cytotoxic T lymphocytes in cancer patients. This SART1antigen may be useful in specific immunotherapy for cancer patients and may serve as a paradigmatic tool for the diagnosis and treatment of patients with atopy. The SART1protein is found to be essential for the recruitment of the tri-snRNP to the pre-spliceosome in the spliceosome assembly pathway.
仅用于科研。不用于诊断过程。未经明确授权不得转售。
篇参考文献 (0)
生物信息学
蛋白别名: hSART-1; hSnu66; hypoxia associated factor; Hypoxia-associated factor; IgE autoantigen; MGC2038; mSART-1; rSART-1; SART-1; SART1(259) protein; SART1(800) protein; SART1, U4/U6.U5 tri-snRNP-associated protein 1; small nuclear ribonucleoprotein 110kDa (U4/U6.U5); SNU66 homolog; squamous cell carcinoma antigen recognised by T cells; Squamous cell carcinoma antigen recognized by T-cells 1; U4/U6.U5 tri-snRNP-associated 110 kDa protein; U4/U6.U5 tri-snRNP-associated protein 1; unnamed protein product
基因别名: Ara1; HAF; HOMS1; SART1; SART1259; SNRNP110; Snu66; U5-110K
UniProt ID: (Human) O43290, (Mouse) Q9Z315, (Rat) Q5XIW8
Entrez Gene ID: (Human) 9092, (Mouse) 20227, (Rat) 29678